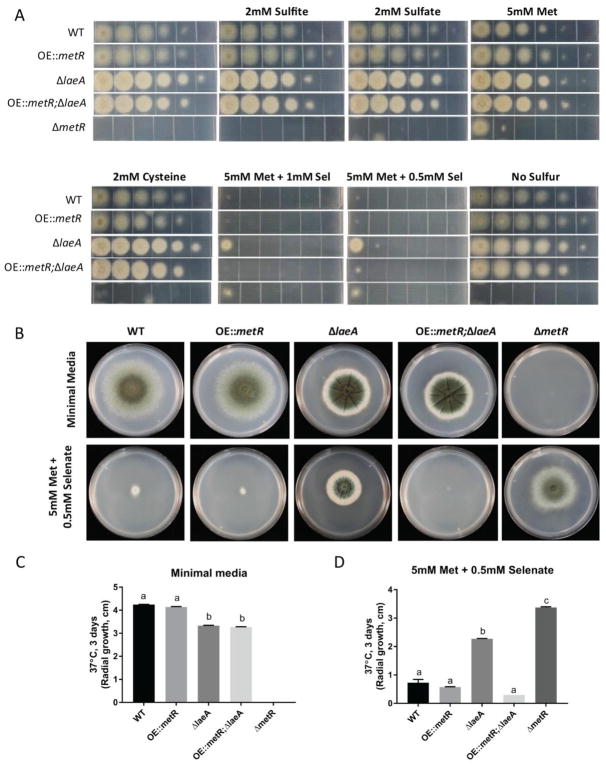

Abstract
LaeA is a conserved global regulator of secondary metabolism and development in filamentous fungi. Examination of Aspergillus fumigatus transcriptome data of laeA deletion mutants have been fruitful in identifying genes and molecules contributing to the laeA mutant phenotype. One of the genes significantly down regulated in A. fumigatus ΔlaeA is metR, encoding a bZIP DNA binding protein required for sulfur and methionine metabolism in fungi. LaeA and MetR deletion mutants exhibit several similarities including down regulation of sulfur assimilation and methionine metabolism genes and ability to grow on the toxic sulfur analog, sodium selenate. However, unlike ΔmetR, ΔlaeA strains are able to grow on sulfur, sulfite, and cysteine. To examine if any parameter of the ΔlaeA phenotype is due to decreased metR expression, an over-expression allele (OE::metR) was placed in a ΔlaeA background. The OE::metR allele could not significantly restore expression of MetR regulated genes in ΔlaeA but did restore sensitivity to sodium selenate. In A. nidulans a second bZIP protein, MetZ, also regulates sulfur and methionine metabolism genes. However, addition of an OE::metZ construct to the A. fumigatus ΔlaeA OE::metR strain still was unable to rescue the ΔlaeA phenotype to wildtype with regards gliotoxin synthesis and virulence in a zebrafish aspergillosis model.
Keywords: Aspergillus fumigatus, sulfur metabolism, transcription factors, selenate
Introduction
The filamentous fungus Aspergillus fumigatus is an opportunistic human pathogen frequently associated with diseases including allergic bronchopulmonary aspergillosis, mycotoxicosis, and invasive aspergillosis (IA), this latter disease with mortality rates up to 90% (Abad et al., 2010). Similar to other pathogenic microorganisms, A. fumigatus must obtain nutrients from its host. Indeed, it is becoming evident that blocking nutrient acquisition could be a key to preventing or ameliorating microbial pathogenesis (Abu Kwaik and Bumann, 2013). In its non-pathogenic state, A. fumigatus is a saprophyte and widespread in nature, obtaining nutrients from dead and decaying organic matter. Because of its saprophytic life cycle and thermo-tolerance, it is able to survive in variable environmental conditions and successfully compete for nutrients (Fleck et al., 2011).
Metabolic attributes of fungi play a significant role in pathogenicity. Recently, several studies have linked primary metabolism to the pathogenicity of fungi, including but not limited to nitrogen and carbon metabolism and availability of essential micronutrients like zinc, copper and iron (reviewed in (Boral et al., 2017)). For example, A. fumigatus is known to produce several siderophores including ferricrocin, ferrichrome, ferrichrome C, and N′,N″,N-triacetylfusarinine C (TAF) out of which ferricrocin and TAF were found to be most abundant. These metabolites are required for iron scavenging for the fungus and deletion of sidA, encoding l-ornithine N 5-monooxygenase which is the first committed step in siderophore synthesis, generated a strain unable to grow either in vitro or in vivo in multiple vertebrate models of IA including murine and zebrafish models (Hissen et al., 2005; Knox et al., 2014; Schrettl et al., 2004). Copper homeostasis is also important in A. fumigatus virulence as it was shown that AceA and MacA (Mac1), transcription factors required for Cu mediated defense responses, are essential for pathogenesis in neutropenic models of IA depending on fungal strain (Cai et al., 2017; Wiemann et al., 2017). These are but a few examples where nutrient acquisition has been associated with the pathogenicity and overall survival of the fungus.
The ability of the fungus to adapt to its environment – be it as a saprophyte or pathogen – is multifactorial ranging from genes and molecules involved in primary metabolism to secondary metabolism. LaeA is one of the major virulence factors in A. fumigatus which was discovered in 2004 as a global regulator of secondary metabolism in Aspergillus spp. (Bok and Keller, 2004). LaeA is part of a conserved transcriptional complex in ascomycete fungi involved in orchestrating development with metabolism (Amaike and Keller, 2009; Bok and Keller, 2004; Jain and Keller, 2013; Lopez-Berges et al., 2013; Seiboth et al., 2012). Loss of this gene results in decreased virulence in all pathogenic fungi examined to date (Lopez-Berges et al., 2013; Wiemann et al., 2010; Wu et al., 2012) including A. fumigatus where laeA deletants were found aberrant in spore production, invasive growth and secondary metabolism (Ben-Ami et al., 2009; Bok et al., 2005; Dagenais and Keller, 2009; Sugui et al., 2007). The pleiotropic nature of LaeA was revealed from transcriptional microarray studies of laeA deletants where numerous genes and molecules involved in virulence and nutrient acquisition were mis-regulated compared to wild-type including some genes involved in the aforementioned siderophore and copper homeostasis pathways (Perrin et al., 2007). Among these genes were several LaeA regulated transcription factors potentially contributing to the fitness and virulence defects of the ΔlaeA strain. For example, nosA, encoding a Zn(II)(2)Cys(6) transcription factor important in sexual development in A. nidulans (Vienken and Fischer, 2006) and significantly up-regulated in A. fumigatus ΔlaeA, was found to contribute to a germination defect of ΔlaeA mutants (Soukup et al., 2012).
Another class of transcription factors (TFs) are the basic leucine zipper (bZIP) domain TFs, a conserved family of TFs regulating diverse metabolic and stress response pathways in eukaryotes (Piłsyk et al., 2015; Wee et al., 2017). Filamentous fungi typically contain well over a dozen of these TFs (Kong et al., 2015). bZIPs typically form homo or hetero-dimers and bind to the promotor regions to regulate the transcription of their target genes. Several fungal bZIPs have been characterized and implicated in multiple phenomena including remediation of secondary metabolism (Sekonyela R et al., 2013), virulence (Amich et al., 2013; Kong et al., 2015; Schrettl et al., 2010), and the oxidative stress response (Wee et al., 2017). A connection between bZIP proteins and laeA have been found in both A. flavus and A. nidulans. In the former, the bZIP nitrogen regulatory gene meaB is overexpressed in the A. flavus ΔlaeA mutant and creation of synthetic meaB overexpression strains were found to mimic the OE::laeA phenotype (Amaike et al., 2013; Shaaban et al., 2010). The A. nidulans bZIP protein RsmA was identified in a multicopy-suppressor screen to find genes that could remediate laeA loss. Overexpression of rsmA was able to restore production of sterigmatocystin via transcriptional activation of sterigmatocystin biosynthetic genes (Shaaban et al., 2010).
In A. fumigatus, the bZIP MetR, which positively affects the transcriptional activation of sulfur assimilation and methionine anabolic genes in Aspergillus spp., is required for virulence (Amich et al., 2013; Natorff et al., 2003). MetR mutants are easily detected not only by inability to grow without added methionine to the medium but also to the resistance of metR mutants to selenate, a toxin taken up by sulfate permeases (which are not expressed in metR mutants, (Arst, 1968; Brzywczy et al., 2011). The regulation of sulfur metabolism by MetR might be more complex than originally thought as another TF (named MetZ) containing a bZIP domain similar to MetR was identified and described in A. nidulans (Piłsyk et al., 2015). metZ expression was not only dependent on MetR but it was also found to be under the regulation of sulfur metabolite repression (SMR) system unlike MetR itself. The SMR system allows for tight regulation of transcription of sulfur assimilation genes by selectively activating the TFs depending on sulfur status of the cell. Thus it was deduced that MetZ seems to be controlling the sulfur assimilation genes by fine tuning their expression (Piłsyk et al., 2015).
Because a previous transcriptional profiling study showed that both metZ, metR and many MetR regulated genes showed lower expression levels in ΔlaeA when compared to wild-type (Perrin et al., 2007), here we investigated if either MetR or MetZ contributed to the ΔlaeA phenotype in A. fumigatus. We hypothesized that downregulation of metR in particular could contribute to some of the phenotypes associated with laeA loss, including resistance to selenate, down regulation of sulfur/methionine assimilation/anabolic genes and reduced virulence (reviewed in (Jain and Keller, 2013). To address this question, we overexpressed either metR alone or in combination with metZ in the ΔlaeA background. Although the overexpression strains gained a wild type sensitivity to selenate, there was little increase in MetR regulated gene expression and no restoration of wild type virulence in a zebrafish model of invasive aspergillosis.
Materials and Methods
Fungal strains and culture conditions
The strains and plasmids used in this study are listed in Table 1. All strains were grown at either 37°C or 25°C with appropriate supplements (2 mM methionine, 1.26 g/L uridine, and 0.56 g/L uracil). The strains were stored as glycerol stocks at −80°C.
Physiological studies
103 conidia from each strain were point-inoculated (5 μl) onto solid glucose minimal media (GMM) (Shimizu and Keller, 2001) in three biological replicates and incubated at 25°C for 12 days and at 37°C for 5 days. Two mM methionine was used as a supplement for all strains when ΔmetR was included in an experiment. Radial growth was assayed by measuring the diameter of point-inoculated colonies after 5 days and 12 days incubation at 37°C and 25°C, respectively. Conidia were counted from agar cores taken from the center of the point-inoculated cultures.
Sulfur and methionine utilization
Dilution plating was performed with the strains on MM-S (minimal media minus sulfur) with different sulfur sources. Different sulfur sources included sodium sulfate (2 mM), sodium sulfite (2 mM), L-methionine (5 mM), L-methionine (5 mM) + sodium selenate (0.5 mM and 1 mM), and cysteine (2 mM). Glucose minimal media (GMM) and MM-S were used as a control. Dilution plating was done from 105 spores to 100 spores in 1 μl. The plates were incubated at 37°C for 48 hours.
Northern analysis
The strains were analyzed for gene expression using standard Northern blotting procedure. 107 fungal spores/ml were grown in liquid minimal media for either 24 hours at 37°C or 60 hours at 25°C shaking at 250 r.p.m. Total RNA was extracted using Isol-RNA Lysis Reagent (5 Prime) as described previously (Sambrook J, 2001). Approximately 20 μg of total RNA was used for blotting. Blots were hybridized with DNA fragments generated by PCR of wild-type (WT) gDNA with gene specific primers (Table 2).
Semi-quantitative RT-PCR analysis
Semi-qRT-PCR analysis was performed using 10 μg RNA which was digested with DNAse I (NEB Cat# M0303L) to remove any contaminating genomic DNA. cDNA synthesis reactions were performed using the Bio-Rad iScript cDNA Synthesis Kit (Cat# 170-8891) according to manufacturer’s protocols. 50 ng of cDNA was used per reaction to amplify specific fragments using gene specific primers (Table 2).
Quantitative RT-PCR analysis
qRT-PCR analysis was performed using 10 μg RNA which was digested with DNAse I (NEB Cat# M0303L) to remove any contaminating genomic DNA. cDNA synthesis reactions were performed using the Bio-Rad iScript cDNA Synthesis Kit (Cat# 170-8891) according to manufacturer’s protocols. 50 ng of cDNA was used per reaction to amplify using gene specific primers (Table 2). qRT-PCR was performed using a Sensi FAST SYBR® No-ROX Kit (Bioline USA Inc., Taunton, MA, USA) on a CFX96 real-time PCR system (Bio-Rad). Relative quantification data were calculated for each gene using the threshold cycle (ΔΔCT) method with actin as an internal control and normalization to the wild type. Statistical significance was measured using analysis of variance (ANOVA) in GraphPad Prism v6, and comparisons to the wild type were done using Dunnett’s test.
Transformation and genetic manipulation
Fungal transformation was done as previously described (Palmer et al., 2008). The construct for the overexpression of metR was made using double-joint PCR (Szewczyk et al., 2006; Yu et al., 2004). Briefly, approximately 1.5-kb 5’ flanking region was PCR amplified from gDNA of AF293 and fused to the A. parasiticus pyrG::gpdA (P) from plasmid pJMP9 and the metR open reading frame (primers are listed in Table 2). The laeA gene was disrupted with A. fumigatus argB in the AF293.6 (pyrG1, argB1) background to create TJMP19.2 (ΔlaeA, pyrG1). Over expression of metR was achieved by transformation of the construct into AF293.1 (pyrG1) and TJMP19.2 (ΔlaeA, pyrG1), which created TRSR22.1 (OE::metR) and TRSR22.3 (ΔlaeA, OE::metR) respectively. These strains were confirmed by Southern and northern blot (Fig S-1A–B and Fig S-2A). Deletion of metR was achieved by using double joint PCR (Szewczyk et al., 2006; Yu et al., 2004). Approximately 1 Kb of the 5’ and 3’ flanking region was PCR amplified from gDNA of AF293 and fused to A. parasiticus pyrG gene from pJMP7. The deletion cassette was transformed into AF293.1 (pyrG1) to generate TSJA1.1 (ΔmetR) which was confirmed by Southern and northern blotting (Fig S-1C and Fig S-2B). The construct for overexpression of both metR and metZ was assembled using homologous recombination in yeast from an adapted protocol (van Leeuwen et al., 2015). Briefly, metR ORF including terminator regions, metZ ORF including terminator regions, and niiA niaD divergent promoter were amplified from Af293 gDNA and fused with A. parasiticus pyrG amplified from pJMP9. The above fragments contained 20–35 bp overlapping bases to the correct flanking fragments for in vivo yeast recombination to create pSJA1. Plasmids were confirmed by restriction digests and sequencing. The overexpression construct was then transformed into a wild type background Af293.1 (pyrG1) generating TSJA2.1 (OE::metRmetZ) and a ΔlaeA background TJMP19.2 (ΔlaeA, pyrG1) generating TSJA3.1 (OE::metRmetZ; ΔlaeA). All strains were confirmed by PCR, Southern, and northern blotting. Both OE::metRmetZ and OE::metRmetZ; ΔlaeA were always grown on minimal media with nitrate as nitrogen source to induce over-expression including when grown for northern analysis.
Gliotoxin Analysis
Strains were assessed for gliotoxin production. Briefly, 5 × 106 conidia per ml were inoculated into 125ml flasks containing 50ml liquid minimal media. Strains were grown at 25°C for 3 days shaking at 250rpm. Three-day old cultures were harvested, mycelia was filtered and 5 ml of culture supernatant was extracted with 5ml of organic solvent (ethyl acetate). The top layer of the ethyl acetate was then taken off and instantly dried in a speed-vac. Dried extracts were re-suspended in 50% acetonitrile, filtered through 0.2μ filters, and analyzed on HPLC. The gliotoxin peak was identified by comparing with purified standard bought from Sigma (Cat#: G9893).
Pathogenicity
Virulence was assessed in a vertebrate model of invasive aspergillosis using larval zebrafish as previously described (Knox et al., 2014) with slight modifications. Based on previous studies showing a requirement for functional neutrophils to observe a virulence attenuation for the A. fumigatus ΔlaeA strain (Knox et al., 2014), all infections were performed in macrophage-deficient irf8−/− larvae in which neutrophils retain function (Shiau et al., 2015). Briefly, conidial stocks in PBS at a concentration of 1.5 × 108 cells/mL were mixed with 1% phenol red to obtain a final injection concentration of 1.0 × 108. Spore suspensions were microinjected at a volume of 3 nL/larvae and localized to the hindbrain ventricle of anesthetized 48 hours post fertilization larvae. Each infected larva was housed individually in a single well of a 96-well plate in ~100 μL of E3-MB and stored at 28.5 °C for the duration of each 7-day survival assay. Mortality was determined by lack of detectable heartbeat. Statistical analysis for survival assays were performed by pooling 3 independent experimental replicates and generating P values via Cox proportional hazards regression analysis.
Results
LaeA regulates expression of sulfur assimilation and methionine metabolism genes
In 2007, Perrin et al. conducted a genome wide transcriptional microarray study with an A. fumigatus ΔlaeA mutant compared to wild-type. This study revealed that metR and metZ were downregulated (2 fold and 1.5-fold respectively) in the ΔlaeA mutant. MetR and MetZ are bZIP transcription factors regulating the transcription of genes involved in sulfur assimilation, methionine and cysteine metabolism in Aspergillus spp. (Amich et al., 2013; Natorff et al., 2003). Further analysis of the microarray data for the genes associated with sulfur assimilation and methionine metabolism indicated that many of the genes in the pathway were significantly down-regulated in ΔlaeA as compared to wild-type (Fig 1 and Table 3) (Perrin et al., 2007).
Figure 1. Sulfur/methionine assimilation pathway in yeast with their homologs in A. fumigatus (reformatted from (Thomas and Surdin-Kerjan, 1997).
The genes shown in red are significantly down-regulated in ΔlaeA compared to wild-type as analyzed in Perrin et al., 2007.
Overexpression of metR does not restore expression of sulfur assimilation genes in ΔlaeA
To determine if decreased expression of metR was responsible for the decreased transcription of the sulfur/methionine pathway genes in ΔlaeA, two over-expression (OE) strains were created through standard transformation processes (OE::metR and OE::metR;ΔlaeA) (Fig S-1A–B and Fig S-2A). Gene expression was assessed using quantitative RT-PCR in all the strains as compared to wild-type and ΔlaeA controls. The decrease in expression of these genes, including metR itself, was largely confirmed in the ΔlaeA strain (Fig 2). However, the OE::metR allele had little impact on these genes in either the wild-type or ΔlaeA background, suggesting a need for additional transcriptional machinery for MetR function.
Figure 2. qRT-PCR analysis of select genes in A. fumigatus strains.
Relative gene expression of each gene in OE::metR, ΔlaeA, and OE::metRΔlaeA A. fumigatus strains is shown. metR and Act1 (Afu6g04740) serve as a control. Expression of each gene was normalized to Actin (Act1) and relative expression was calculated by comparing to wild type. Asterisks in the figure indicate statistical significance (*, **, ***, *** indicating p-value <0.05, 0.01,0.001, 0.0001 respectively). Labels on top indicate gene annotations in Aspergillus nidulans, labels in parenthesis indicate yeast homologs.
MetR overexpression does not restore wild type sporulation to ΔlaeA
Although we did not see an increase in expression in the sulfur/methionine pathway genes in the OE::metR strains, we considered it possible that this allele might impact other aspects of the ΔlaeA phenotype. Thus OE::metR and OE::metR;ΔlaeA strains were assessed for any ability to restore ΔlaeA phenotypes to wild type growth, in particular colony growth and sporulation. The OE::metR;ΔlaeA was unable to restore wild type characteristics in any of these parameters as shown in Fig 3a–c (radial growth) and Fig 3d–e (spore production). Radial growth and sporulation of OE::metR was comparable to wild-type (Fig 3a–e).
Figure 3. Radial growth and sporulation of A. fumigatus strains.
A. 103 conidia from wild-type, OE::metR, ΔlaeA, and OE::metRΔlaeA strains were point inoculated on glucose minimal media and incubated at both 25°C and 37°C for 12 days and 5 days respectively. Pictures of top of the plates are shown. B and C. Radial growth was quantified and plotted using GraphPad Prism software. Levels not connected by the same letter are significantly different (p<0.05) according to a 1 way ANOVA test. D and E. Spores from each strain were counted using a haemocytometer. Means ± standard deviations are indicated for three replicates of each strain. Levels not connected by same letter are significantly different (P>0.05) according to a 1way ANOVA test.
Over-expressing metR in ΔlaeA background restores sensitivity to the toxic sulfur analog selenate
Sodium selenate is a toxic analog of sulfate that has been used to identify Aspergillus nidulans sulfur assimilation mutants including mutations in sulfate permeases (Sul1 and Sul2), ATP sulfurylase and PAPS reductase (Arst, 1968; Natorff et al., 2003). The most distinct characteristics of ΔmetR and sulfur assimilation mutants are their inability to grow on several sulfur sources and resistance to sodium selenate. As shown in Fig 4a, ΔlaeA exhibited wild type growth on medium supplemented with sulfite, sulfate, methionine and cysteine but exhibited a ΔmetR phenotype of enhanced growth on sodium selenate supplemented medium compared to wild type. OE::metR in a ΔlaeA background, on the other hand, restored sensitivity to selenate as the double mutant grew much slower than ΔlaeA as indicated by its decreased radial growth (Fig 4a). This was confirmed by point inoculation on agar plates and quantifying the radial growth (Fig 4b–d).
Figure 4. Sulfur and methionine utilization of A. fumigatus strains.
A. Dilution plating was performed with wild-type, OE::metR, ΔlaeA, OE::metRΔlaeA and ΔmetR strains on MM-S (minimal media minus sulfur) with different sulfur sources. Different sulfur sources included sodium sulfate (2mM), sodium sulfite (2mM), L-methionine (5mM), L-methionine (5mM) + sodium selenate (0.5mM and 1mM), and cysteine (2mM). Glucose minimal media (GMM) and MM-S were used as a control. Dilution plating was done from 105 spores to 100 spores in 1μl. The plates were incubated at 37°C for 48 hours. B. Strains were grown on glucose minimal media and MM-S with 5mM L-methionine and 0.5mM sodium selenate at 37°C for 3 days. C and D. Radial growth was quantified by measuring diameters and plotting them using GraphPad Prism software. Means ± standard deviations are indicated for three replicates of each strain. Levels not connected by same letter are significantly different (P>0.05) according to a 1 way ANOVA test.
Addition of a MetZ overexpression construct does not restore a wild type developmental or gliotoxin phenotype to ΔlaeA
Considering that a second bZIP transcription factor MetZ works in possible coordination with MetR in A. nidulans, we considered that over-expressing the A. fumigatus homolog of MetZ could be important in restoration of some of the ΔlaeA phenotypes. Thus we generated two over-expression strains, OE::metRmetZ, and OE::metRmetZΔlaeA (Fig S-3A–B and Fig S-4). These strains were assessed for colony growth and sporulation. The OE::metRmetZΔlaeA was unable to restore wild type characteristics in any of these parameters as shown in Fig 5a (radial growth), Fig 5b (spore production). Radial growth and sporulation of OE::metRmetZ was comparable to wild-type (Fig 5a–e). However the OE::metRmetZ; ΔlaeA strain was sensitive to selenate, similar to that of OE::metR;ΔlaeA and wild-type (Fig 6a–c).
Figure 5. Average radial growth of of A. fumigatus strains.
A. 103 conidia from wild-type, OE::metRmetZ, ΔlaeA, and OE::metRmetZΔlaeA strains were point inoculated on glucose minimal media and incubated at both 25°C and 37°C for 12 days and 5 days respectively. Pictures of top of the plates are shown. B and C. Radial growth was quantified and plotted using GraphPad Prism software. Levels not connected by the same letter are significantly different (p<0.05) according to a 1 way ANOVA test. D and E. Spores were counted using a haemocytometer. Means ± standard deviations are indicated for three replicates of each strain. Levels not connected by same letter are significantly different (P>0.05) according to a 1way ANOVA test.
Figure 6. Selenate sensitivity assay of A. fumigatus strains.
A. Wild-type, OE::metRmetZ, ΔlaeA, and OE::metRmetZΔlaeA strains were grown on glucose minimal media and MM-S with 5mM L-methionine and 0.5mM sodium selenate at 37°C for 3 days. B and C. Radial growth was quantified using ImageJ (area) and plotting using GraphPad Prism software. Means ± standard deviations are indicated for three replicates of each strain. Levels not connected by same letter are significantly different (P>0.05) according to a 1 way ANOVA test.
LaeA is a known positive regulator of the toxin gliotoxin (Bok and Keller, 2004). Thus we were also interested to determine any impact of OE::metR and OE::metRmetZ; on gliotoxin synthesis, especially due to the known interplay of gliotoxin metabolism and the methyl/methionine cycle (Owens et al., 2015). As shown in supplementary Fig S-6, gliotoxin synthesis remained depressed in all strains harboring a ΔlaeA allele.
Overexpression of metR and metZ in the ΔlaeA background does not impact the virulence attenuation of ΔlaeA in immunosuppressed zebrafish larvae
With LaeA being a known virulence factor, we next investigated whether reconstitution of metR and metZ expression in a ΔlaeA background would restore virulence. While LaeA is a known pathogenicity factor in several models of invasive aspergillosis, the mechanism(s) underlying LaeA’s role in pathogenicity remain largely unknown. To this end, we utilized the larval zebrafish as a vertebrate model of invasive aspergillosis to test if MetR or MetZ had a measurable impact on LaeA-mediated pathogenicity. Importantly, our data (Fig 7) recapitulate the previously described virulence attenuation for a ΔlaeA strain of A. fumigatus compared to an isogenic control in macrophage-deficient larvae (Knox et al., 2014). Overexpression of metR and metZ in a ΔlaeA background, however, failed to produce any significant change in virulence. Additionally, overexpression of metR and metZ alone was insufficient to alter the virulence in reference to an isogenic control (Fig 7).
Figure 7. Virulence in a vertebrate model of invasive aspergillosis.
Infections were performed using macrophage-deficient irf8−/− zebrafish larvae at 2 days post fertilization and individual larvae followed for survival through 7 days post infection (dpi). Survival data shown on a Kaplan-Meier plot from three pooled independent experimental replicates. Statistical analysis was performed using Cox proportional-hazard regression analysis.
Discussion
LaeA, a nuclear protein affecting global gene expression, is a conserved protein in filamentous fungi and of significant interest due its requirement for morphological and chemical development (Bok and Keller, 2004; Lopez-Berges et al., 2013; Seiboth et al., 2012; Zhang et al., 2016), biofuel enzyme activity (Li et al., 2016; Seiboth et al., 2012) and involvement in virulence of plant, fungal and human pathogenic fungi (Amaike and Keller, 2009; Bi et al., 2013; Karimi Aghcheh et al., 2013; Kumar et al., 2017; Lopez-Berges et al., 2013). Microarray analysis of laeA mutants show LaeA to regulate at least 10 percent of the genome (Fekete et al., 2014; Perrin et al., 2007; Wang et al., 2017). Our interest in metR, encoding a bZIP transcription factor known to regulate sulfur assimilation genes in Aspergillus nidulans and A. fumigatus, developed because the transcript level of this gene was significantly reduced in a ΔlaeA strain (Perrin et al., 2007). Because several of the known phenotypes of the ΔlaeA strain have been attributed to or corrected by mis-regulation of specific TFs (e.g. gliotoxin reduction due to suppression of gliZ, (Bok and Keller, 2004)or germination and radial growth aberrations associated with over expression of nosA, (Soukup et al., 2012), we thought it possible that some ΔlaeA traits could be a consequence of altered metR expression.
As might be expected for a strain with weak metR expression, many MetR regulated genes are down regulated in the ΔlaeA mutant (Fig 1 and 2), similar to reports of ΔmetR mutants (Amich et al., 2013; Brzywczy et al., 2011). Another similarity between ΔlaeA and ΔmetR was their relative resistance to the toxic metabolite selenate (Fig 4 and 6). Previous reports indicate that selenate is taken up by cells through sulfur regulated permeases and is incorporated into sulfur containing compounds (including amino acids). Due to this replacement of S with Se, resulting proteins become non-functional and the fungus starves to death. Enzyme activity associated with Se toxicity include PAPS reductase and ATP sulfurlyase. In 1968, Arst reported that a double sulfur uptake/ATP sulfurylase mutant (the first two steps of the sulfur assimilation pathway, Fig. 1) was able to tolerate roughly fifty times more selenate than a single mutant of PAPS reductase (Arst, 1968; Natorff et al., 2003; Tweedie and Segel, 1970). We speculated that ΔlaeA resistance to selenate might stem from the fact that ATP sulfurlyase (AFU3g06530) and PAPS reductase (AFU3g06540) are downregulated in this mutant, hence selenate is not taken up by the cells as efficiently as in wild-type. Although OE:metR in a ΔlaeA background restored the sensitivity to selenate, the expression of ATP sulfurlyase gene (AFU3g06530) PAPS reductase (AFU3g06540) were not significantly increased in the OE::metR;ΔlaeA double mutant which might suggest other enzymes or permeases involved in selenate transport or possibly post-transcriptional regulation of these enzymes. Moreover, due to broad transcriptional reprogramming that MetR is involved in the cell, we cannot rule out the possibility of non-specific effects of its over-expression.
What makes it particularly more complex is that the transcription factors related to sulfur metabolism are controlled by ubiquitin ligases belonging to SCF family (Sieńko et al., 2014). In A. nidulans, the activity of MetR is dependent on the sulfur status of the cell and controlled by ubiquitin ligases encoded by the scon genes which have homologs in A. fumigatus although not very well characterized. In Schizosaccharomyces pombe Zip1 (MetR) is phosphorylated, allowing it to interact with SCF-Pof1 leading to its degradation (Harrison et al., 2005) and in budding yeast SCF-Met30 complex plays a role in degradation of Met4 (MetZ) (Rouillon et al., 2000). Similarly, it is thought that MetR is repressed under high cellular methionine/cysteine levels consequently repressing the MetR regulated genes (Piłsyk et al., 2015). An assessment of the cellular levels of sulfur/sulfur-containing amino acids present in the A. fumigatus mutants (ΔlaeA and OE::metR;ΔlaeA) could possibly point towards a mechanism for selenate resistance. Moreover, A. fumigatus sulfur acquisition could be different from A. nidulans since some sulfate transporters identified in A. nidulans seems to be absent in A. fumigatus like the astA gene (alternative sulfate transporter) (Piłsyk et al., 2007). Furthermore, considering the pleiotropic effects of LaeA, we speculate that the transcriptional remodeling in OE::metR;ΔlaeA would be different from OE::metR and could also contribute to the different phenotypes.
Because no other wild-type physiological or developmental characteristics were recovered OE:metR;ΔlaeA double mutant, including gene expression of sulfur metabolism genes, we considered that MetR function might require presence of MetZ due to the report that MetZ – only found in the Eurotiales fungal taxon - works in co-ordination with MetR to regulate sulfur and methionine assimilation in A. nidulans (Piłsyk et al., 2015). However, overexpression of both bZIPs MetR and MetZ in the ΔlaeA strain still did not restore gene expression of the downregulated genes of sulfur metabolism pathway in a ΔlaeA background as shown in Fig S-5 for select genes. This may not be surprising after considering the qRT-PCR results (Fig 2) where we found that metZ was significantly downregulated in the OE::metR strains in addition to ΔlaeA strains. This result points, once again, to the complexity of the transcriptional regulation of sulfur metabolism. We speculate that in A. fumigatus, metR and metZ may not necessarily work in synergy consequently overexpressing both bZIPs at the same time may not help in restoring expression of sulfur metabolism genes. However, sensitivity to selenate was again restored, which might solely be due to MetR since OE::metR was equally sensitive to selenate despite reduction in metZ gene expression.
As mentioned earlier, ΔlaeA strains also exhibit reduced ability to produce a gliotoxin, an epipolythiodioxopiperazine alkaloid characterized by a unique disulfide bridge (Bok and Keller, 2004). Our results suggest that gliotoxin production was not restored by over expressing either MetR or MetZ. This may be explained by the fact that although MetR is required for utilization of sulfur sources except methionine (Amich et al., 2013), the biosynthetic gene cluster of gliotoxin on the other hand may be expressed independently of these bZIPs and requires the expression of other TFs like GliZ (Bok and Keller, 2004).
LaeA is also a well-established virulence determinant in plant and animal ascomycete fungal pathogens (reviewed in (Jain and Keller, 2013), yet ascribing the specific pathway(s) regulated by the pleiotropic LaeA to virulence attenuations has remained difficult. Therefore, we hypothesized that overexpression of metR (also a virulence factor, (Amich et al., 2013) and metZ in a ΔlaeA background might restore virulence to wild-type levels in a larval zebrafish model of invasive aspergillosis. As described previously, there is a host immune-specific virulence defect for ΔlaeA exclusively within macrophage-deficient, but not neutrophil-deficient, zebrafish larvae (Knox et al., 2014). From this, we evaluated the role of MetR and MetZ to remediate virulence attenuation in a ΔlaeA strain of A. fumigatus using irf8−/− animals (Shiau et al., 2015). Consistent with most of our other data in which overexpression of metR and metZ fails to restore most of the sulfur- and methionine-related phenotypes of the ΔlaeA strain, we observed no amelioration of virulence attenuation in the ΔlaeA;OE::metRmetZ strain compared to ΔlaeA (Fig 7). Taken together, in light of the metabolic flexibility and redundancy of A. fumigatus pathogenicity (Amich and Krappmann, 2012), restoration of full virulence in a ΔlaeA strain of A. fumigatus will likely not be accomplished through the reinstallation of a single gene or pathway.
This study was motivated from previous reports where synthetic expression of transcription factors regulated by LaeA were able to restore some of the associated ΔlaeA phenotypes (Amaike et al., 2013; Soukup et al., 2012). Here, we report here that despite an overlap in positive regulation of sulfur/methionine assimilation pathway genes by LaeA and MetR, overexpression of metR was unable to rescue the aberrancies associated with ΔlaeA strains except for selenate tolerance. Addition of an overexpression metZ allele – postulated to work in concert with MetR in A. nidulans – displayed an equivalent phenotype as the OE::metR ΔlaeA strain thus also failing to restore sulfur/methionine gene expression. Although restoration of selenate sensitivity in the over-expression strains makes a convincing argument for upregulation of sulfur uptake pathway by MetR, it was difficult to call to a specific mechanism at this point.
Supplementary Material
A. Southern blot analysis of the OEmetR and wild-type strains. Genomic DNA was digested with HindIII and PstI. Expected hybridization band patterns for PstI: 1.951kb, 2.223kb and 3.616kb for mutant, 1.988kb and 2.223kb for wild type strain. Expected hybridization band patterns for HindIII: 4.462kb and 6.770kb for mutant, and 7.653kb for wild type strain. B. Southern Blot analysis for the OEmetR ΔlaeA and wild-type strains. Genomic DNA was digested with HindIII and PstI. Expected hybridization band patterns for PstI: 1.951kb, 2.223kb and 3.616kb for mutant, 1.988kb and 2.223kb for wild-type. Expected hybridization band patterns for HindIII: 4.462kb and 6.770kb for mutant, and 7.653kb for wild-type. C. Southern Blot analysis for the ΔmetR and wild-type strain. Genomic DNA was digested with HindIII and EcoRV. Expected hybridization band patterns for HindIII: 4.462kb and 3.737kb for mutant, and 7.653kb for wild-type. Expected hybridization band patterns for EcoRV: 2.540kb, 4.868kb, 0.645kb for mutant, and 4.253kb and 3.350kb for wild-type strain. Correct strains are indicated by a downward arrow.
Standard Northern blot procedure was followed. Briefly 107 fungal spores/ml were grown in liquid minimal media for 24 hours shaking at 250 r.p.m. Total RNA was extracted using Isol-RNA Lysis Reagent (5 Prime) as described previously (Sambrook J, 2001). Approximately 20 μg of total RNA was used for blotting. Blots were hybridized with DNA fragments generated by PCR of wild-type (WT) gDNA with gene specific primers. An internal fragment of metR open reading frame was used as a probe. rRNA serves as a control here.
A. Southern blot analysis of the OEmetRmetZ ΔlaeA and wild-type strains. Genomic DNA was digested with EcoRI and SphI. Expected hybridization band patterns for EcoRI: 10 kb, and 5.3Kb band for mutant, 5.3Kb band for wild type strain. Expected hybridization band patterns for SphI: 12 Kb and 5.4 Kb band for mutant, and 5.4kb for wild type strain. B. Southern Blot analysis for the OEmetRmetZ and wild-type strains. Genomic DNA was digested with EcoRI and SphI. Expected hybridization band patterns for EcoRI: 10 kb, and 5.3Kb band for mutant, 5.3Kb band for wild type strain. Expected hybridization band patterns for SphI: 12 Kb and 5.4 Kb band for mutant, and 5.4kb for wild type strain. Correct strains are indicated by a downward arrow.
Standard Northern blot procedure was followed as explained previously. Briefly 107 fungal spores/ml were grown in liquid minimal media with Nitrate as the Nitrogen source for 24 hours shaking at 250 r.p.m. Total RNA was extracted using Isol-RNA Lysis Reagent (5 Prime) as described previously (Sambrook J, 2001). Approximately 20 μg of total RNA was used for blotting. Blots were hybridized with DNA fragments generated by PCR of wild-type (WT) gDNA with gene specific primers. An internal fragment of metR and metZ open reading frame was used as a probe. rRNA serves as a control here.
Standard semi-qRT PCR of gene expression in wild-type, OE::metRmetZ, ΔlaeA, and OE::metRmetZΔlaeA A. fumigatus. A. PCR product from the RT PCR reactions were run on the 2% agarose gel and picture of the bands are shown. B. The bands from panel A were quantified using ImageJ software. Means ± standard deviations are indicated for three replicates of each strain. Levels not connected by same letter are significantly different (P>0.05) according to a 1 way ANOVA test.
Figure S6. Gliotoxin analysis. Wild type, ΔlaeA, and over-expression strains were assessed for gliotoxin production. Average peak area of three biological replicates is shown. Levels not connected by same letter are significantly different (P>0.05) according to a 1 way ANOVA test.
Supplemental Table 1. Aspergillus fumigatus strains used in this study
Supplemental Table 2. List of Primers used in this study
Supplemental Table 3. List of genes involved in the sulfur assimilation pathway in yeast with their homologs in Aspergillus fumigatus and their function. The column labeled “ΔlaeA” shows normalized expression ratio values (average of three biological replicates) for ΔlaeA vs wild-type with values >= 1.0 indicating genes that are significantly down-regulated. The values were normalized using LOWESS normalization method and the statistical analysis was performed using Significance analysis of microarrays (SAM) method (Perrin et al., 2007).
Highlights.
Sulfur metabolism genes are downregulated in laeA deletion mutants.
ΔlaeA mutants are resistant to selenate (toxic analog of sulfate).
Over-expression of metR and metZ restores selenate sensitivity in ΔlaeA mutants.
Over-expression of metR and metZ does not restore other ΔlaeA abberancies.
Acknowledgments
This work was supported by NIH grant R01 AI065728-01 to NPK.
Footnotes
Publisher's Disclaimer: This is a PDF file of an unedited manuscript that has been accepted for publication. As a service to our customers we are providing this early version of the manuscript. The manuscript will undergo copyediting, typesetting, and review of the resulting proof before it is published in its final citable form. Please note that during the production process errors may be discovered which could affect the content, and all legal disclaimers that apply to the journal pertain.
References
- Abad A, Fernandez-Molina JV, Bikandi J, Ramirez A, Margareto J, Sendino J, Hernando FL, Ponton J, Garaizar J, Rementeria A. What makes Aspergillus fumigatus a successful pathogen? Genes and molecules involved in invasive aspergillosis. Rev Iberoam Micol. 2010:155–182. doi: 10.1016/j.riam.2010.10.003. [DOI] [PubMed] [Google Scholar]
- Abu Kwaik Y, Bumann D. Microbial quest for food in vivo: ‘nutritional virulence’ as an emerging paradigm. Cell Microbiol. 2013;15:882–890. doi: 10.1111/cmi.12138. [DOI] [PubMed] [Google Scholar]
- Amaike S, Affeldt KJ, Yin WB, Franke S, Choithani A, Keller NP. The bZIP protein MeaB mediates virulence attributes in Aspergillus flavus. PLoS One. 2013;8:e74030. doi: 10.1371/journal.pone.0074030. [DOI] [PMC free article] [PubMed] [Google Scholar]
- Amaike S, Keller NP. Eukaryot Cell. United States: 2009. Distinct roles for VeA and LaeA in development and pathogenesis of Aspergillus flavus; pp. 1051–1060. [DOI] [PMC free article] [PubMed] [Google Scholar]
- Amich J, Krappmann S. Deciphering metabolic traits of the fungal pathogen Aspergillus fumigatus: redundancy vs. essentiality. Front Microbiol. 2012;3:414. doi: 10.3389/fmicb.2012.00414. [DOI] [PMC free article] [PubMed] [Google Scholar]
- Amich J, Schafferer L, Haas H, Krappmann S. Regulation of sulphur assimilation is essential for virulence and affects iron homeostasis of the human-pathogenic mould Aspergillus fumigatus. PLoS Pathog. 2013;9:e1003573. doi: 10.1371/journal.ppat.1003573. [DOI] [PMC free article] [PubMed] [Google Scholar]
- Arst HN., Jr Genetic analysis of the first steps of sulphate metabolism in Aspergillus nidulans. Nature. 1968;219:268–270. doi: 10.1038/219268a0. [DOI] [PubMed] [Google Scholar]
- Ben-Ami R, Lewis RE, Leventakos K, Kontoyiannis DP. Blood. United States: 2009. Aspergillus fumigatus inhibits angiogenesis through the production of gliotoxin and other secondary metabolites; pp. 5393–5399. [DOI] [PMC free article] [PubMed] [Google Scholar]
- Bi Q, Wu D, Zhu X, Gillian Turgeon B. Cochliobolus heterostrophus Llm1 - a Lae1-like methyltransferase regulates T-toxin production, virulence, and development. Fungal Genet Biol. 2013;51:21–33. doi: 10.1016/j.fgb.2012.11.012. [DOI] [PubMed] [Google Scholar]
- Bok JW, Balajee SA, Marr KA, Andes D, Nielsen KF, Frisvad JC, Keller NP. Eukaryot Cell. United States: 2005. LaeA, a regulator of morphogenetic fungal virulence factors; pp. 1574–1582. [DOI] [PMC free article] [PubMed] [Google Scholar]
- Bok JW, Keller NP. LaeA, a regulator of secondary metabolism in Aspergillus spp. Eukaryot Cell. 2004;3:527–535. doi: 10.1128/EC.3.2.527-535.2004. [DOI] [PMC free article] [PubMed] [Google Scholar]
- Boral H, Metin B, Döğen A, Seyedmousavi S, Ilkit M. Overview of selected virulence attributes in Aspergillus fumigatus, Candida albicans, Cryptococcus neoformans, Trichophyton rubrum, and Exophiala dermatitidis. Fungal Genet Biol. 2017 doi: 10.1016/j.fgb.2017.10.008. [DOI] [PubMed] [Google Scholar]
- Brzywczy J, Kacprzak MM, Paszewski A. Novel mutations reveal two important regions in Aspergillus nidulans transcriptional activator MetR. Fungal Genet Biol. 2011;48:104–112. doi: 10.1016/j.fgb.2010.10.002. [DOI] [PubMed] [Google Scholar]
- Cai Z, Du W, Zeng Q, Long N, Dai C, Lu L. Cu-sensing transcription factor Mac1 coordinates with the Ctr transporter family to regulate Cu acquisition and virulence in Aspergillus fumigatus. Fungal Genet Biol. 2017;107:31–43. doi: 10.1016/j.fgb.2017.08.003. [DOI] [PubMed] [Google Scholar]
- Dagenais TR, Keller NP. Clin Microbiol Rev. United States: 2009. Pathogenesis of Aspergillus fumigatus in Invasive Aspergillosis; pp. 447–465. [DOI] [PMC free article] [PubMed] [Google Scholar]
- Fekete E, Karaffa L, Karimi Aghcheh R, Németh Z, Orosz A, Paholcsek M, Stágel A, Kubicek CP. The transcriptome of lae1 mutants of Trichoderma reesei cultivated at constant growth rates reveals new targets of LAE1 function. BMC Genomics. 2014;15:447. doi: 10.1186/1471-2164-15-447. [DOI] [PMC free article] [PubMed] [Google Scholar]
- Fleck CB, Schobel F, Brock M. Int J Med Microbiol. Elsevier GmbH; Germany: 2011. Nutrient acquisition by pathogenic fungi: nutrient availability, pathway regulation, and differences in substrate utilization; pp. 400–407. [DOI] [PubMed] [Google Scholar]
- Harrison C, Katayama S, Dhut S, Chen D, Jones N, Bähler J, Toda T. SCF(Pof1)-ubiquitin and its target Zip1 transcription factor mediate cadmium response in fission yeast. EMBO J. 2005;24:599–610. doi: 10.1038/sj.emboj.7600536. [DOI] [PMC free article] [PubMed] [Google Scholar]
- Hissen AH, Wan AN, Warwas ML, Pinto LJ, Moore MM. The Aspergillus fumigatus siderophore biosynthetic gene sidA, encoding L-ornithine N5-oxygenase, is required for virulence. Infect Immun. 2005;73:5493–5503. doi: 10.1128/IAI.73.9.5493-5503.2005. [DOI] [PMC free article] [PubMed] [Google Scholar]
- Jain S, Keller N. Insights to fungal biology through LaeA sleuthing. Fungal Biology Reviews. 2013;27:51–59. [Google Scholar]
- Karimi Aghcheh R, Druzhinina IS, Kubicek CP. The putative protein methyltransferase LAE1 of Trichoderma atroviride is a key regulator of asexual development and mycoparasitism. PLoS One. 2013;8:e67144. doi: 10.1371/journal.pone.0067144. [DOI] [PMC free article] [PubMed] [Google Scholar]
- Knox BP, Deng Q, Rood M, Eickhoff JC, Keller NP, Huttenlocher A. Distinct innate immune phagocyte responses to Aspergillus fumigatus conidia and hyphae in zebrafish larvae. Eukaryot Cell. 2014;13:1266–1277. doi: 10.1128/EC.00080-14. [DOI] [PMC free article] [PubMed] [Google Scholar]
- Kong S, Park SY, Lee YH. Systematic characterization of the bZIP transcription factor gene family in the rice blast fungus, Magnaporthe oryzae. Environ Microbiol. 2015;17:1425–1443. doi: 10.1111/1462-2920.12633. [DOI] [PubMed] [Google Scholar]
- Kumar D, Barad S, Chen Y, Luo X, Tannous J, Dubey A, Glam Matana N, Tian S, Li B, Keller N, Prusky D. LaeA regulation of secondary metabolism modulates virulence in Penicillium expansum and is mediated by sucrose. Mol Plant Pathol. 2017;18:1150–1163. doi: 10.1111/mpp.12469. [DOI] [PMC free article] [PubMed] [Google Scholar]
- Li Y, Zheng X, Zhang X, Bao L, Zhu Y, Qu Y, Zhao J, Qin Y. The Different Roles of Penicillium oxalicum LaeA in the Production of Extracellular Cellulase and β-xylosidase. Front Microbiol. 2016;7:2091. doi: 10.3389/fmicb.2016.02091. [DOI] [PMC free article] [PubMed] [Google Scholar]
- Lopez-Berges MS, Hera C, Sulyok M, Schafer K, Capilla J, Guarro J, Di Pietro A. The velvet complex governs mycotoxin production and virulence of Fusarium oxysporum on plant and mammalian hosts. Mol Microbiol. 2013;87:49–65. doi: 10.1111/mmi.12082. [DOI] [PubMed] [Google Scholar]
- Natorff R, Sienko M, Brzywczy J, Paszewski A. Mol Microbiol. England: 2003. The Aspergillus nidulans metR gene encodes a bZIP protein which activates transcription of sulphur metabolism genes; pp. 1081–1094. [DOI] [PubMed] [Google Scholar]
- Owens RA, O’Keeffe G, Smith EB, Dolan SK, Hammel S, Sheridan KJ, Fitzpatrick DA, Keane TM, Jones GW, Doyle S. Interplay between Gliotoxin Resistance, Secretion, and the Methyl/Methionine Cycle in Aspergillus fumigatus. Eukaryot Cell. 2015;14:941–957. doi: 10.1128/EC.00055-15. [DOI] [PMC free article] [PubMed] [Google Scholar]
- Palmer JM, Perrin RM, Dagenais TR, Keller NP. H3K9 methylation regulates growth and development in Aspergillus fumigatus. Eukaryot Cell. 2008;7:2052–2060. doi: 10.1128/EC.00224-08. [DOI] [PMC free article] [PubMed] [Google Scholar]
- Perrin RM, Fedorova ND, Bok JW, Cramer RA, Wortman JR, Kim HS, Nierman WC, Keller NP. PLoS Pathog. United States: 2007. Transcriptional regulation of chemical diversity in Aspergillus fumigatus by LaeA; p. e50. [DOI] [PMC free article] [PubMed] [Google Scholar]
- Piłsyk S, Natorff R, Sieńko M, Paszewski A. Sulfate transport in Aspergillus nidulans: a novel gene encoding alternative sulfate transporter. Fungal Genet Biol. 2007;44:715–725. doi: 10.1016/j.fgb.2006.11.007. [DOI] [PubMed] [Google Scholar]
- Piłsyk S, Natorff R, Sieńko M, Skoneczny M, Paszewski A, Brzywczy J. The Aspergillus nidulans metZ gene encodes a transcription factor involved in regulation of sulfur metabolism in this fungus and other Eurotiales. Curr Genet. 2015;61:115–125. doi: 10.1007/s00294-014-0459-5. [DOI] [PubMed] [Google Scholar]
- Rouillon A, Barbey R, Patton EE, Tyers M, Thomas D. Feedback-regulated degradation of the transcriptional activator Met4 is triggered by the SCF(Met30 )complex. EMBO J. 2000;19:282–294. doi: 10.1093/emboj/19.2.282. [DOI] [PMC free article] [PubMed] [Google Scholar]
- Sambrook JRD. Molecular Cloning: A Laboratory Manual. Cold Spring Harbor Laboratory Press; Cold Spring Harbor, NY: 2001. [Google Scholar]
- Schrettl M, Beckmann N, Varga J, Heinekamp T, Jacobsen ID, Jöchl C, Moussa TA, Wang S, Gsaller F, Blatzer M, Werner ER, Niermann WC, Brakhage AA, Haas H. HapX-mediated adaption to iron starvation is crucial for virulence of Aspergillus fumigatus. PLoS Pathog. 2010;6:e1001124. doi: 10.1371/journal.ppat.1001124. [DOI] [PMC free article] [PubMed] [Google Scholar]
- Schrettl M, Bignell E, Kragl C, Joechl C, Rogers T, Arst HN, Jr, Haynes K, Haas H. Siderophore biosynthesis but not reductive iron assimilation is essential for Aspergillus fumigatus virulence. J Exp Med. 2004;200:1213–1219. doi: 10.1084/jem.20041242. [DOI] [PMC free article] [PubMed] [Google Scholar]
- Seiboth B, Karimi RA, Phatale PA, Linke R, Hartl L, Sauer DG, Smith KM, Baker SE, Freitag M, Kubicek CP. The putative protein methyltransferase LAE1 controls cellulase gene expression in Trichoderma reesei. Mol Microbiol. 2012;84:1150–1164. doi: 10.1111/j.1365-2958.2012.08083.x. [DOI] [PMC free article] [PubMed] [Google Scholar]
- Sekonyela R, Palmer JM, Bok JW, Jain S, Berthier E, Forseth R, Schroeder F, Keller N. RsmA, a bZIP protein of Aspergillus fumigatus, regulates gliotoxin gene cluster expression and supports a role for gliotoxin-related products in invasive aspergillosis. PloS One. 2013 doi: 10.1371/journal.pone.0062591. [DOI] [PMC free article] [PubMed] [Google Scholar]
- Shaaban MI, Bok JW, Lauer C, Keller NP. Eukaryot Cell. United States: 2010. Suppressor mutagenesis identifies a velvet complex remediator of Aspergillus nidulans secondary metabolism; pp. 1816–1824. [DOI] [PMC free article] [PubMed] [Google Scholar]
- Shiau CE, Kaufman Z, Meireles AM, Talbot WS. Differential requirement for irf8 in formation of embryonic and adult macrophages in zebrafish. PLoS One. 2015;10:e0117513. doi: 10.1371/journal.pone.0117513. [DOI] [PMC free article] [PubMed] [Google Scholar]
- Shimizu K, Keller NP. Genetic involvement of a cAMP-dependent protein kinase in a G protein signaling pathway regulating morphological and chemical transitions in Aspergillus nidulans. Genetics. 2001;157:591–600. doi: 10.1093/genetics/157.2.591. [DOI] [PMC free article] [PubMed] [Google Scholar]
- Sieńko M, Natorff R, Skoneczny M, Kruszewska J, Paszewski A, Brzywczy J. Regulatory mutations affecting sulfur metabolism induce environmental stress response in Aspergillus nidulans. Fungal Genet Biol. 2014;65:37–47. doi: 10.1016/j.fgb.2014.02.001. [DOI] [PubMed] [Google Scholar]
- Soukup AA, Farnoodian M, Berthier E, Keller NP. NosA, a transcription factor important in Aspergillus fumigatus stress and developmental response, rescues the germination defect of a laeA deletion. Fungal Genet Biol. 2012;49:857–865. doi: 10.1016/j.fgb.2012.09.005. [DOI] [PMC free article] [PubMed] [Google Scholar]
- Sugui JA, Pardo J, Chang YC, Mullbacher A, Zarember KA, Galvez EM, Brinster L, Zerfas P, Gallin JI, Simon MM, Kwon-Chung KJ. Eukaryot Cell. United States: 2007. Role of laeA in the Regulation of alb1, gliP, Conidial Morphology, and Virulence in Aspergillus fumigatus; pp. 1552–1561. [DOI] [PMC free article] [PubMed] [Google Scholar]
- Szewczyk E, Nayak T, Oakley CE, Edgerton H, Xiong Y, Taheri-Talesh N, Osmani SA, Oakley BR. Fusion PCR and gene targeting in Aspergillus nidulans. Nat Protoc. 2006;1:3111–3120. doi: 10.1038/nprot.2006.405. [DOI] [PubMed] [Google Scholar]
- Thomas D, Surdin-Kerjan Y. Metabolism of sulfur amino acids in Saccharomyces cerevisiae. Microbiol Mol Biol Rev. 1997;61:503–532. doi: 10.1128/mmbr.61.4.503-532.1997. [DOI] [PMC free article] [PubMed] [Google Scholar]
- Tweedie JW, Segel IH. Specificity of transport processes for sulfur, selenium, and molybdenum anions by filamentous fungi. Biochim Biophys Acta. 1970;196:95–106. doi: 10.1016/0005-2736(70)90170-7. [DOI] [PubMed] [Google Scholar]
- van Leeuwen J, Andrews B, Boone C, Tan G. Rapid and Efficient Plasmid Construction by Homologous Recombination in Yeast. Cold Spring Harb Protoc. 2015 doi: 10.1101/pdb.prot085100. pdb.prot085100. [DOI] [PubMed]
- Vienken K, Fischer R. The Zn(II)2Cys6 putative transcription factor NosA controls fruiting body formation in Aspergillus nidulans. Mol Microbiol. 2006;61:544–554. doi: 10.1111/j.1365-2958.2006.05257.x. [DOI] [PubMed] [Google Scholar]
- Wang B, Lv Y, Li X, Lin Y, Deng H, Pan L. Profiling of secondary metabolite gene clusters regulated by LaeA in Aspergillus niger FGSC A1279 based on genome sequencing and transcriptome analysis. Res Microbiol. 2017 doi: 10.1016/j.resmic.2017.10.002. [DOI] [PubMed] [Google Scholar]
- Wee J, Hong SY, Roze LV, Day DM, Chanda A, Linz JE. The Fungal bZIP Transcription Factor AtfB Controls Virulence-Associated Processes in Aspergillus parasiticus. Toxins (Basel) 2017:9. doi: 10.3390/toxins9090287. [DOI] [PMC free article] [PubMed] [Google Scholar]
- Wiemann P, Brown DW, Kleigrewe K, Bok JW, Keller NP, Humpf HU, Tudzynski B. FfVel1 and FfLae1, components of a velvet-like complex in Fusarium fujikuroi, affect differentiation, secondary metabolism and virulence. Mol Microbiol. 2010 doi: 10.1111/j.1365-2958.2010.07263.x. [DOI] [PMC free article] [PubMed] [Google Scholar]
- Wiemann P, Perevitsky A, Lim FY, Shadkchan Y, Knox BP, Landero Figueora JA, Choera T, Niu M, Steinberger AJ, Wüthrich M, Idol RA, Klein BS, Dinauer MC, Huttenlocher A, Osherov N, Keller NP. Aspergillus fumigatus Copper Export Machinery and Reactive Oxygen Intermediate Defense Counter Host Copper-Mediated Oxidative Antimicrobial Offense. Cell Rep. 2017;19:2174–2176. doi: 10.1016/j.celrep.2017.05.075. [DOI] [PubMed] [Google Scholar]
- Wu D, Oide S, Zhang N, Choi MY, Turgeon BG. PLoS Pathog. United States: 2012. ChLae1 and ChVel1 regulate T-toxin production, virulence, oxidative stress response, and development of the maize pathogen Cochliobolus heterostrophus; p. e1002542. [DOI] [PMC free article] [PubMed] [Google Scholar]
- Yu JH, Hamari Z, Han KH, Seo JA, Reyes-Dominguez Y, Scazzocchio C. Fungal Genet Biol. United States: 2004. Double-joint PCR: a PCR-based molecular tool for gene manipulations in filamentous fungi; pp. 973–981. [DOI] [PubMed] [Google Scholar]
- Zhang X, Zhu Y, Bao L, Gao L, Yao G, Li Y, Yang Z, Li Z, Zhong Y, Li F, Yin H, Qu Y, Qin Y. Putative methyltransferase LaeA and transcription factor CreA are necessary for proper asexual development and controlling secondary metabolic gene cluster expression. Fungal Genet Biol. 2016;94:32–46. doi: 10.1016/j.fgb.2016.07.004. [DOI] [PubMed] [Google Scholar]
Associated Data
This section collects any data citations, data availability statements, or supplementary materials included in this article.
Supplementary Materials
A. Southern blot analysis of the OEmetR and wild-type strains. Genomic DNA was digested with HindIII and PstI. Expected hybridization band patterns for PstI: 1.951kb, 2.223kb and 3.616kb for mutant, 1.988kb and 2.223kb for wild type strain. Expected hybridization band patterns for HindIII: 4.462kb and 6.770kb for mutant, and 7.653kb for wild type strain. B. Southern Blot analysis for the OEmetR ΔlaeA and wild-type strains. Genomic DNA was digested with HindIII and PstI. Expected hybridization band patterns for PstI: 1.951kb, 2.223kb and 3.616kb for mutant, 1.988kb and 2.223kb for wild-type. Expected hybridization band patterns for HindIII: 4.462kb and 6.770kb for mutant, and 7.653kb for wild-type. C. Southern Blot analysis for the ΔmetR and wild-type strain. Genomic DNA was digested with HindIII and EcoRV. Expected hybridization band patterns for HindIII: 4.462kb and 3.737kb for mutant, and 7.653kb for wild-type. Expected hybridization band patterns for EcoRV: 2.540kb, 4.868kb, 0.645kb for mutant, and 4.253kb and 3.350kb for wild-type strain. Correct strains are indicated by a downward arrow.
Standard Northern blot procedure was followed. Briefly 107 fungal spores/ml were grown in liquid minimal media for 24 hours shaking at 250 r.p.m. Total RNA was extracted using Isol-RNA Lysis Reagent (5 Prime) as described previously (Sambrook J, 2001). Approximately 20 μg of total RNA was used for blotting. Blots were hybridized with DNA fragments generated by PCR of wild-type (WT) gDNA with gene specific primers. An internal fragment of metR open reading frame was used as a probe. rRNA serves as a control here.
A. Southern blot analysis of the OEmetRmetZ ΔlaeA and wild-type strains. Genomic DNA was digested with EcoRI and SphI. Expected hybridization band patterns for EcoRI: 10 kb, and 5.3Kb band for mutant, 5.3Kb band for wild type strain. Expected hybridization band patterns for SphI: 12 Kb and 5.4 Kb band for mutant, and 5.4kb for wild type strain. B. Southern Blot analysis for the OEmetRmetZ and wild-type strains. Genomic DNA was digested with EcoRI and SphI. Expected hybridization band patterns for EcoRI: 10 kb, and 5.3Kb band for mutant, 5.3Kb band for wild type strain. Expected hybridization band patterns for SphI: 12 Kb and 5.4 Kb band for mutant, and 5.4kb for wild type strain. Correct strains are indicated by a downward arrow.
Standard Northern blot procedure was followed as explained previously. Briefly 107 fungal spores/ml were grown in liquid minimal media with Nitrate as the Nitrogen source for 24 hours shaking at 250 r.p.m. Total RNA was extracted using Isol-RNA Lysis Reagent (5 Prime) as described previously (Sambrook J, 2001). Approximately 20 μg of total RNA was used for blotting. Blots were hybridized with DNA fragments generated by PCR of wild-type (WT) gDNA with gene specific primers. An internal fragment of metR and metZ open reading frame was used as a probe. rRNA serves as a control here.
Standard semi-qRT PCR of gene expression in wild-type, OE::metRmetZ, ΔlaeA, and OE::metRmetZΔlaeA A. fumigatus. A. PCR product from the RT PCR reactions were run on the 2% agarose gel and picture of the bands are shown. B. The bands from panel A were quantified using ImageJ software. Means ± standard deviations are indicated for three replicates of each strain. Levels not connected by same letter are significantly different (P>0.05) according to a 1 way ANOVA test.
Figure S6. Gliotoxin analysis. Wild type, ΔlaeA, and over-expression strains were assessed for gliotoxin production. Average peak area of three biological replicates is shown. Levels not connected by same letter are significantly different (P>0.05) according to a 1 way ANOVA test.
Supplemental Table 1. Aspergillus fumigatus strains used in this study
Supplemental Table 2. List of Primers used in this study
Supplemental Table 3. List of genes involved in the sulfur assimilation pathway in yeast with their homologs in Aspergillus fumigatus and their function. The column labeled “ΔlaeA” shows normalized expression ratio values (average of three biological replicates) for ΔlaeA vs wild-type with values >= 1.0 indicating genes that are significantly down-regulated. The values were normalized using LOWESS normalization method and the statistical analysis was performed using Significance analysis of microarrays (SAM) method (Perrin et al., 2007).